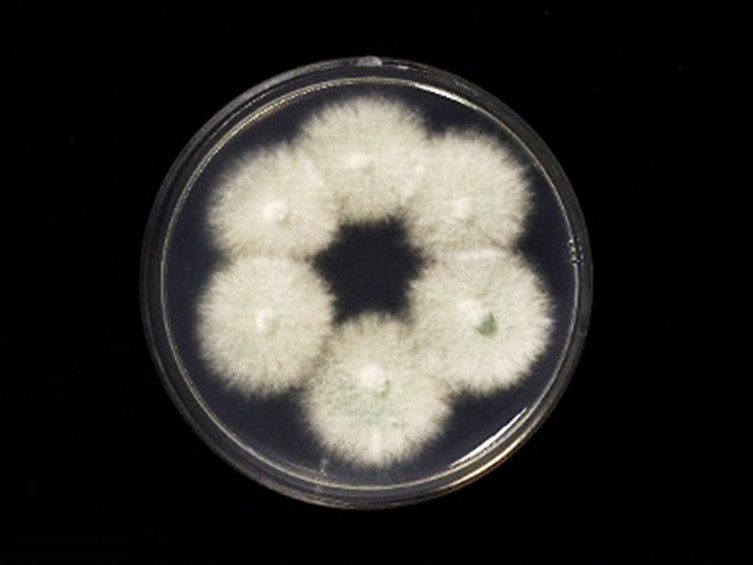

Holotype:
THAILAND, Chaiyaphum Province, Phukhiao Wildlife Sanctuary, 13 Aug. 2015, S. Mongkolsamrit, A. Khonsanit, N. Kobmoo, D. Thanakitpipattana, W. Noisripoom, P. Srikittikulchai, S. Wongkanoun, R. Promhan, holotype BBH 41326, ex-type living culture BCC 78198.
Habitat:
Buried in the ground.
Host:
Cicada nymph (Hemiptera).
Description:
 Stromata arising from the head of the cicada nymphs, solitary or multiple, simple or 2-3 branched, greyish yellow to yellowish olive green, straight, cylindrical, 30-35 mm long. Fertile area on the upper part of the stroma tapering or rounded, 10-15 mm long, 1-1.2 mm thick; terminal part mostly sterile, white to cream.
Stromata arising from the head of the cicada nymphs, solitary or multiple, simple or 2-3 branched, greyish yellow to yellowish olive green, straight, cylindrical, 30-35 mm long. Fertile area on the upper part of the stroma tapering or rounded, 10-15 mm long, 1-1.2 mm thick; terminal part mostly sterile, white to cream.  Perithecium ovoid to obpyriform, immersed, 550-670 × 320-380 μm, oblique in arrangement.
Perithecium ovoid to obpyriform, immersed, 550-670 × 320-380 μm, oblique in arrangement.  Asci cylindrical, 520-650 × 3-4 μm.
Asci cylindrical, 520-650 × 3-4 μm.  Ascospores hyaline, filiform, 225-375 × 1 μm, smooth-walled, multi-septate with cells 9-21.5 μm long, remaining whole after discharge (non-fragmenting).
Ascospores hyaline, filiform, 225-375 × 1 μm, smooth-walled, multi-septate with cells 9-21.5 μm long, remaining whole after discharge (non-fragmenting).  Asexual morph found only on adult cicada of the genus Platypleura (Hemiptera, Cicadidae). Conidiophores arising all over the adult cicada, at first white turning green due to the production of conidia.
Asexual morph found only on adult cicada of the genus Platypleura (Hemiptera, Cicadidae). Conidiophores arising all over the adult cicada, at first white turning green due to the production of conidia.
Culture characteristics:
Colonies on PDA attaining a diam of 18 mm in 7 d, at first white turning to parrot green due to heavy sporulation, velvety to floccose. Colony reverse cream to pale green. Mycelium hyaline, branched, septate, smooth-walled. Conidiophores consisting of divergent, terminal, often verticillate metulae, broadly clavate, or cylindrical, 5–9 × 2–3 μm, smooth-walled. Phialides hyaline, ovoid or ellipsoidal, appressed, 5–8 × 2–3 μm. Conidia catenulate, dimorphic; microconidia formed first, ovoid, ellipsoidal or subglobose, 2–4 × 2–3 μm, macroconidia formed later, cylindrical, clavate, 4–9 × 2–3 μm.
Colonies on PDA attaining a diam of 18 mm in 7 d, at first white turning to parrot green due to heavy sporulation, velvety to floccose. Colony reverse cream to pale green. Mycelium hyaline, branched, septate, smooth-walled. Conidiophores consisting of divergent, terminal, often verticillate metulae, broadly clavate, or cylindrical, 5–9 × 2–3 μm, smooth-walled. Phialides hyaline, ovoid or ellipsoidal, appressed, 5–8 × 2–3 μm. Conidia catenulate, dimorphic; microconidia formed first, ovoid, ellipsoidal or subglobose, 2–4 × 2–3 μm, macroconidia formed later, cylindrical, clavate, 4–9 × 2–3 μm.
Reference:
Mongkolsamrit S, Khonsanit A, Thanakitpipattana D, et al. (2020). Revisiting Metarhizium and the description of new species from Thailand. Studies in Mycology 95: 171–251.
DOI: https://doi.org/10.1016/j.simyco.2020.04.001Species |
Strain |
Compound |
Pubchem CID |
Biological activity |
Reference |
|---|
|
Strain |
ITS | LSU | RPB1 | RPB2 | SSU | TEF1 |
|---|---|---|---|---|---|---|
| BCC 28241 | MN781884 | MN781831 | MN781740 | MN781784 | MN781932 | MN781684 |
| BCC 78198 | MT078881 | KX369593 | KX369594 | KX369595 | KX369596 | KX369592 |